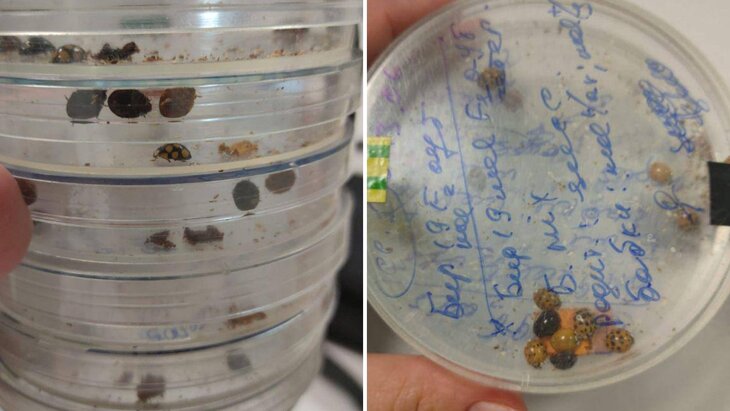

11 августа 2022, 17:45
ОбществоПассажир забыл контейнеры с божьими коровками в метро Москвы
Фото: представлено пресс-службой Московского метрополитена
Пассажир забыл контейнеры с божьими коровками на станции метро "Китай-город" в Москве. Об этом сообщила пресс-служба столичного Дептранса.
Насекомых передали на Склад забытых вещей, который расположен на станции метро "Котельники". Обычно животных всегда передают в приют, но хозяин насекомых приехал до этого момента. Он пояснил, что коллекционирует божьих коровок.
В результате перемещений ни одна божья коровка не пострадали, отметили в департаменте.
"Вы часто забываете свои вещи в метро. Мы передаем их на Склады забытых вещей. Если вы что-то потеряли, обязательно обращайтесь туда", – говорится в сообщении.
Ранее сообщалось, что на станции "Бульвар Рокоссовского" обнаружили клетку с лисой, забытую пассажиром московского метро. Животное передали в приют благотворительного фонда защиты животных "БИМ". Тогда в столичном Дептрансе выразили надежду, что лису будет искать хозяин.








Собянин рассказал, как преобразятся школьные территории к новому учебному году



























